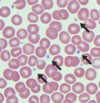

why is anaemia common in cats?
cats mask illness and disease so are diagnosed later
lifespan of cat RBC is shorter than that of a dog
total RBC mass lower in cats than dogs
feline haemoglobin has low affinity for O2
what is the effect of the shortened lifespan of feline RBC?
anaemia is a clinical issue more quickly as functional RBC are lost quicker
what does it mean if RBC have low affinity for oxygen?
O2 is given up to tissues easily
what is the effect of low feline haemoglobin affinity for oxygen?
anaemia better tolerated
what are the clinical signs of anaemia?
pale MM
less commonly: yellow MM
lethargic
weak
hyperdynamic pulses
tachycardia
heart murmur
tachypnoea
enlarged LN and spleen
pica
why is heart murmur seen with anaemia?
altered viscosity of blood changes the flow of blood through the heart
what is the murmur seen with anaemia known as?
haemic murmur
when is an enlarged spleen seen with anaemia?
when it is linked to RBC breakdown and removal
what is the first investigation used for anaemia?
haematology (PCV)
blood smear
what effect does acute haemorrhage have on blood and RBC volume?
PCV will appear normal as volume has been lost
are animals anaemic following acute haemorrhage?
yes - reduced O2 carrying capacity
what is seen on PCV with chronic anaemia?
reduced proportion of RBC to plasma
PCV low
what is seen on PCV with volume overload?
normal RBC volume but increased blood volume so PCV appears low
what is the fundamental issue seen with anaemia?
not enough RBC
what are the 2 types of anaemia?
regenerative
non regenerative
what are the signs seen on blood smear of regenerative anaemia?
reticulocytes >50x10^9/L
anisocytosis
polychromasia
MCV increased
MCHC increased
what are the signs of non-regenerative anaemia seen on blood smear?
reticulocytes <50x10^9/L
normocytic
normochromatic
MCV normal
MCHC normal
what number of reticulocytes are seen with regenerative anaemia?
> 50x10^9/L
what number of reticulocytes are seen with non-regenerative anaemia?
<50x10^9/L
what are reticulocytes?
immature RBC sent into circulation to make up for RBC deficit
what is anisocytosis?
variation in cell size
what is polychromasia?
variation in RBC color density
why is MCV increased with regenerative anaemia?
RBC are larger as immature and sent from the bone marrow before they have shrunk
why is MCHC decreased in regenerative anaemia?
cells are less concentrated when they are reticulocytes